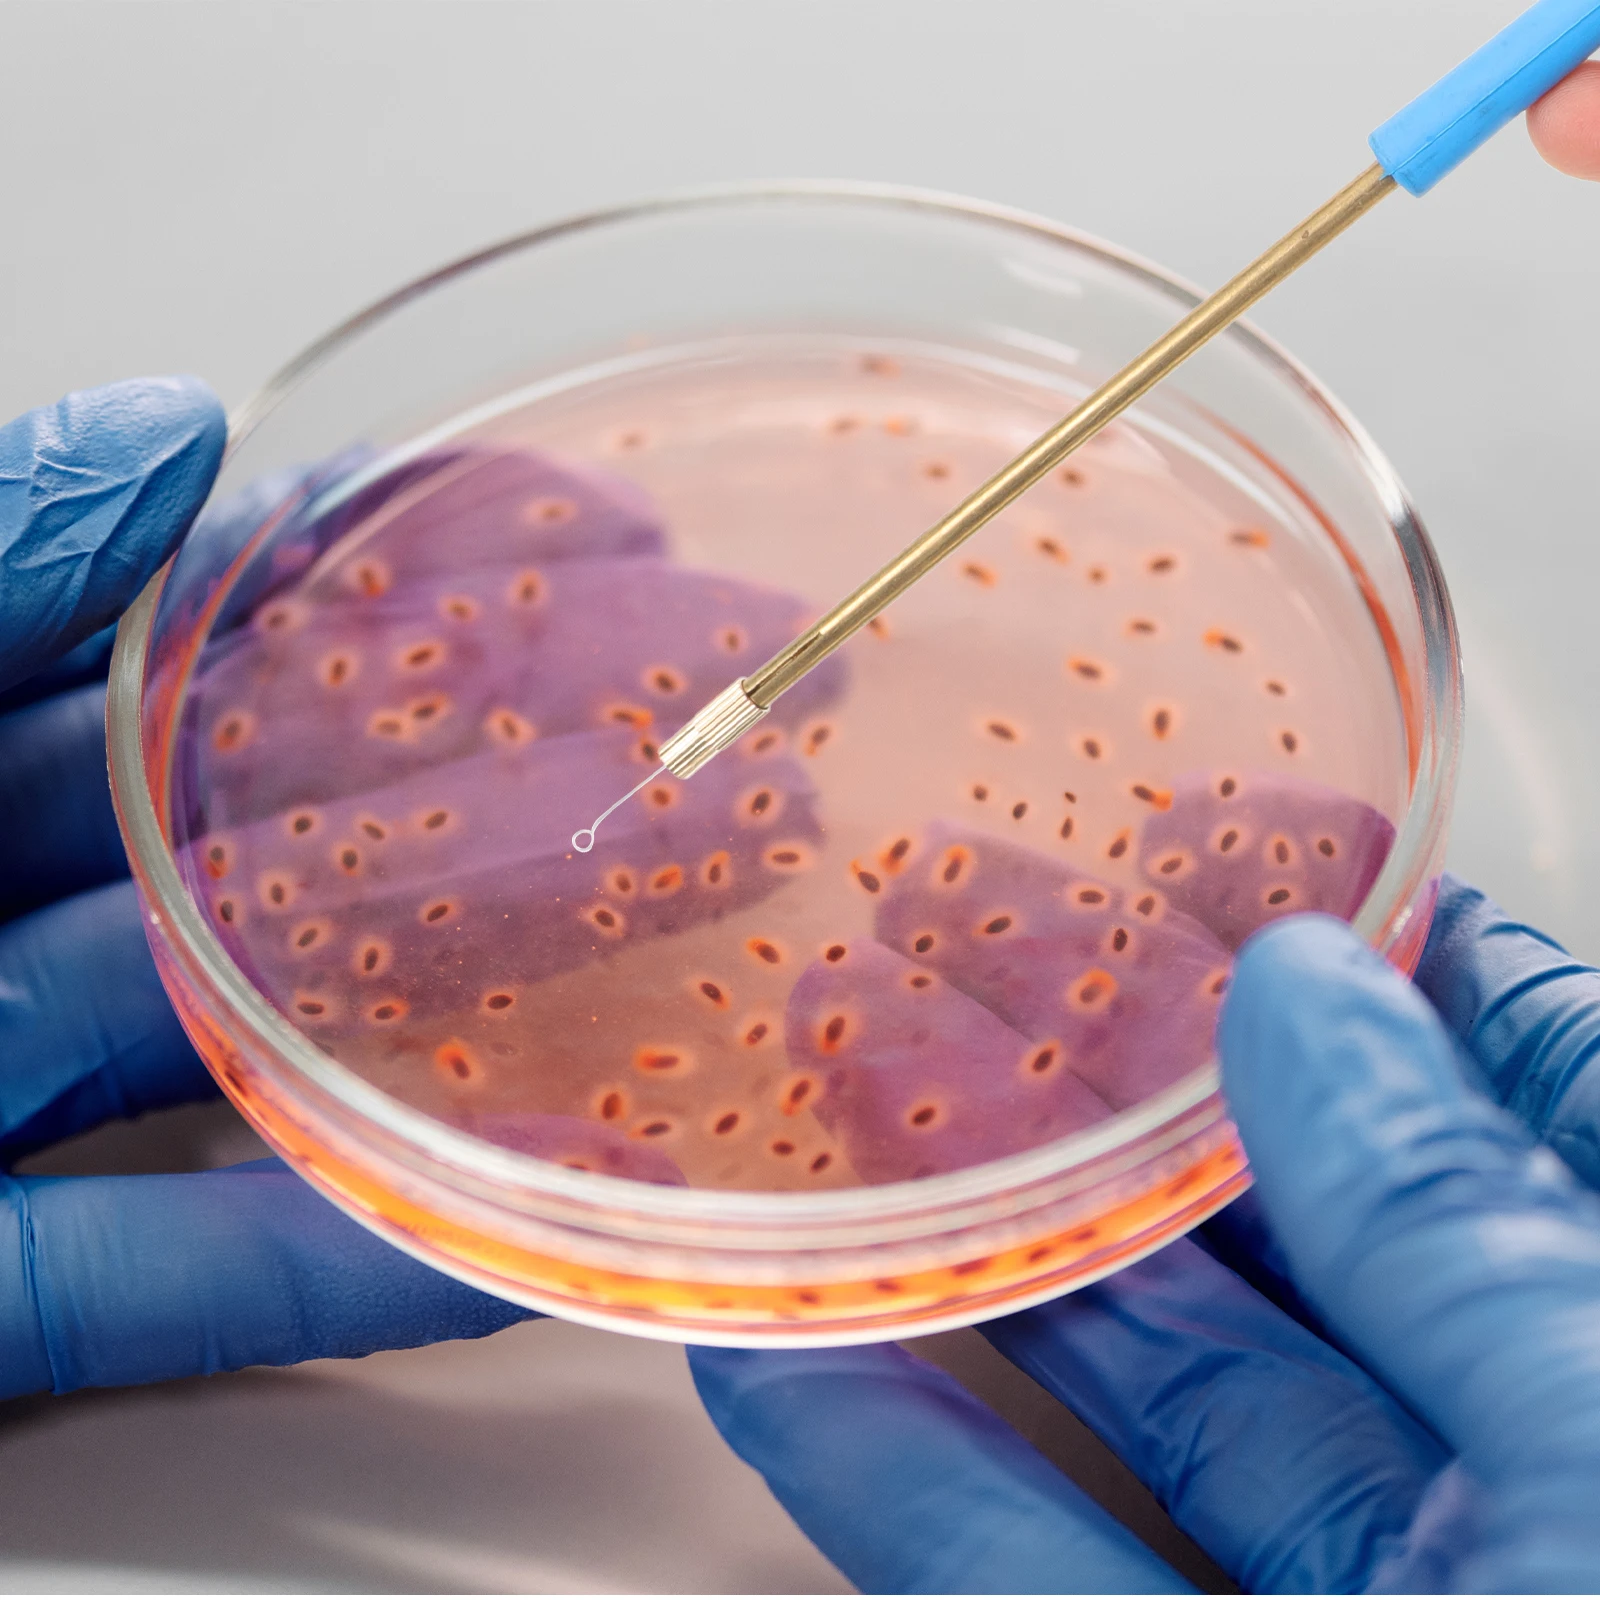

Турбокомпрессор Turbo GT22 GT2259LS 801897 766237 17201 E0080 для автобуса Hino, грузовика Liesse II л, двигатель W04D N04C-TK N04C N04CTK














sku: 1005004935193489
ACCORDING TO OUR RECORDS THIS PRODUCT IS NOT AVAILABLE NOW
$325.27
Shipping from: China
Price history chart & currency exchange rate
Customers also viewed

$410.62
FREE SHIPPING ! Beautiful and Romantic 10ft x 15ft (3m x 4.5m) Aluminum Wedding Party Gazebo, Pop Up Tent, Event Marquee, Awning
aliexpress.com
$1.17
Drop Ship 10 Pairs/lot Japanese Style Handmade Crisscross False Eyelashes Eyes Makeup 170613
aliexpress.com
$25.47
Portable Oral Irrigator USB Rechargeable Water Flosser Water Jet Water Tank Waterproof Teeth Cleaner
aliexpress.com
$2.50
2pc 30mm x5mm-5 NdFeB Ring Magnet Dia. 30x5 mm thick M5 straight Hole Neodymium Rare Earth Permanent Magnet 30*5-5mm
aliexpress.com
$14.45
C11P1612 Аккумулятор для ASUS Zenfone 4 Max Pro Plus ZC554KL X00ID 5,5 "6900 мАч Аккумуляторы большой емкости Инструменты Гарантия
aliexpress.ru
$24.76
Новая цифровая видеокамера 3C-1080P HD с мгновенной печатью, детская цифровая камера для малышей, подарки для девочек и мальчиков 3-12 лет
aliexpress.ru
$6.30
Женская металлическая оправа в форме кошачьего глаза для девочек, плоские линзы, очки без мощности, модный милый дизайн, оправа фиолетового цвета
aliexpress.ru
$1.00
Wooden Bead Cross Pendant Prayer Beads Crosses Necklace for Women Necklaces Metal Colorful Beaded Miss
aliexpress.ru
$4.92
1 set Simulated Seafood Decoration Fake Fish Props Artificial Small Fish Faux Food Models for Restaurant Scene Photography Home
aliexpress.ru
$1,160.20
Tom AutoWRC Style Carbon Fiber Hood for 2012-2020 GT86 BRZ Carbon Fiber Engine Hood Fireproof Bonnet Covers
aliexpress.ru
$153.05
LK280 небольшая Bluetooth машина для нумерации проводов, принтер для цифровых трубок, машина для кодирования термоусадочных трубок LK300
aliexpress.ru
$87.16
Amirah Cloak Элегантные женские платья для свадебной вечеринки Бальные платья на заказ Платья для выпускного вечера с рыбьим хвостом 2025 с открытыми плечами
aliexpress.ru
$15.79
Паяльная сварочная станция, 1 ПК, 120-480 градусов, 6 контактов, керамическая ручка постоянного тока 26 В, паяльник высокого качества, портативный
aliexpress.ru
$12.32
Рубашка для кормления, одежда для беременных, летняя повседневная одежда с короткими рукавами для кормления грудью, футболки с цветочным принтом для беременных женщин
aliexpress.ru
$8.33
Сменные приводные ремни пылесоса, 4 шт. резиновые ремни для вертикальных моделей пылесосов xl
aliexpress.ru
$0.75
Trapezoidal Outline Reflective Delineators Driveway Road Reflectors Polycarbonate Plastic Replacement Pavement Markers Highway
aliexpress.ru
$16.41
6 книг/набор, книжки-раскраски принцессы для взрослых и детей, снимающие стресс, убивайте время, живопись, манга, комиксы, книги для рисования мультфильмов
aliexpress.ru
$449.28
Эргономичный эстетический обеденный стул с акцентом, золотые роскошные ножки, дизайнерский стол для еды, дешевая полная мебель, шезлонги, ясли
aliexpress.ru
$256.66
Скалолазание I'DS Descender D020 Rescue ID Anti-Panic Автоматическая остановка IDS Big Turtle RIG
aliexpress.ru
$54.34
WAIRHEAT WR30 30D 30S фен 3300 Вт машина для запечатывания хвоста машина для бумажных стаканчиков нагреватель фен
aliexpress.ru
$48.48
Автомобильный инвертор 4000 Вт, 12 В до 110 В/220 В, трансформатор напряжения с ЖК-дисплеем, модифицированный синусоидальный зарядный преобразователь, универсальная вилка
aliexpress.ru
$98.58
Dragon Diamond 69 мм насадка для вращающегося устройства, захват с тремя патронами, вращающаяся расширительная ось для волоконной лазерной маркировочной машины
aliexpress.ru
$28.64
Магнитный фиксирующий пояс для ограничения лодыжки, медицинский удерживающий пояс для самовозвращения, хлопковый ремень для лодыжки
aliexpress.ru
$128.78
Для Chrysler Grand Voyager Tourng 2005 2006 2007 2008 2009 2010 задние фонари поворотники задние фонари стоп-сигналы дальнего света
aliexpress.ru